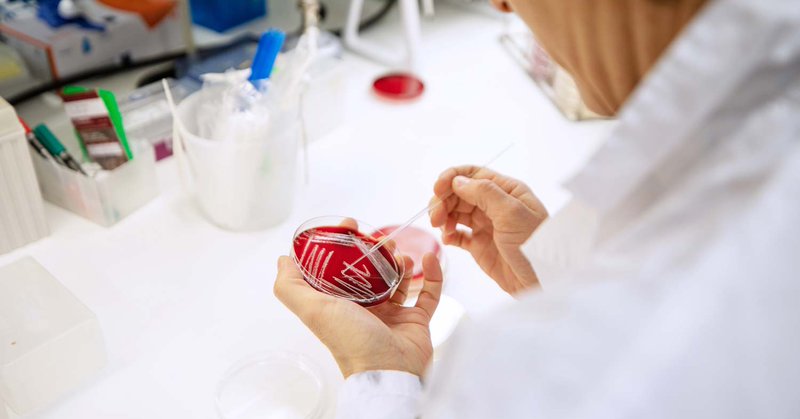
Tweet card summary image

Gabriel MF Almeida
@Gabriel_MFA
Followers
456
Following
1K
Media
56
Statuses
425
Moving from twitter to @gabrielmfa.bsky.social .
Tromsø - Norway
Joined January 2020
What started as a question in a @cans_uit seminar ended up in tying an old and clinically valuable phage to a new bacterial threat described at the UiT. Thanks @jopaca_pauline @RobLavigne1 et al for the collaboration! https://t.co/GPPOQoK1PF
virologyj.biomedcentral.com
Background Staphylococcal infections, caused by a large variety of species within the Staphylococcus genus, are a threat to human health. Although antibiotics are the current choice of treatment for...
0
0
3
New research published in The Lancet finds that Western unilateral sanctions have caused 38 million deaths since 1970. The average death toll ranges from 400,000 to over 1 million per year. Staggering levels of violence. This system is intolerable and must be replaced.
119
3K
7K
We reached over 500 people with the 1st Brazilian symposium of viruses of microbes, followed by one in Alfenas and a phage isolation course. It is rewarding to see a high interest from the younger generation! Looking forward to see the South American VoM field grow. @cans_uit
1
1
18
28 million deaths caused by the imperial core since 1971, due to unilateral sanctions alone. Pure barbarism. This system is incompatible with humanity.
thelancet.com
Sanctions have substantial adverse effects on public health, with a death toll similar to that of wars. Our findings underscore the need to rethink sanctions as a foreign-policy tool, highlighting...
18
742
2K
New research published by the Lancet finds that economic sanctions imposed by the USA and EU are associated with more than 500,000 deaths per year since 1970, five times more than deaths by war.
thelancet.com
Financing for global health is the main topic of discussion in 2025, especially since the Fourth International Conference on Financing for Development in Seville earlier this month. This issue...
40
2K
3K
In light of the public statement made by U.S. President Donald Trump on social media on the afternoon of Wednesday (9), it is important to highlight the following: Brazil is a sovereign nation with independent institutions and will not accept any form of tutelage. The judicial
8K
31K
210K
https://t.co/BqlXCTuPPs "Your new medicine can be a virus" - small discussion about phage therapy, with a Norwegian perspective and updates from the BFE-NFH Marine Bioprospecting group. @cans_uit @UiTNorgesarktis
uitmagasin.no
0
4
11
It is not everyday that we can name a virus after a city! Long effort finally out now, adding Finland to the giant virus map. On top of this, in-depth structural data. Thanks @AbresciaL @sundberglr et al. https://t.co/0qMORtuvT9
@cans_uit
elifesciences.org
Jyvaskylavirus, the northernmost isolate of the Marseilleviridae family, shows that giant viruses are also part of the boreal Finnish environment and brings structural information with relevance for...
2
0
13
Please spread the word! We have an opening in the Atkinson lab for a post-doc with a focus on molecular mechanisms of microbial immune systems. Can be a fully computational or experimental or hybrid project. Read more & apply here: https://t.co/LhJTT4nPtr
#phage #Bioinformatics
lu.varbi.com
Description of the Workplace In the Atkinson lab we are interested in making discoveries about protein function and structure, with a focus on bacterial immune system components that protect against b
1
100
178
What's striking about capitalist civilization is that it has no real direction. There's no vision for social progress, no commitment to improving human welfare or ecology. All we get is the chaos of profit-oriented production and accumulation as the world burns around us.
658
3K
11K
Phage VAC3 adaptations to the mucosal environment can exploited as a prophylactic measure to protect mice from a lethal dose of P. aeruginosa. https://t.co/bABeBIeNAQ
@Gabriel_MFA @cans_uit @UiTNorgesarktis
nature.com
Communications Biology - Phage VAC3 adaptations to the mucosal environment (improved replication in mucin-treated hosts and retention in the respiratory tract) are mechanisms that can exploited as...
0
2
10
First paper on a collaboration between the @cans_uit (Norway) and @unifalmgOFICIAL (Brazil). This paper strengthens mucosal adaptations as the reason why prophylactic phage therapy works and also is symbolic in the revival of phage research in Brazil. https://t.co/IkSSJ0rwyY
nature.com
Communications Biology - Phage VAC3 adaptations to the mucosal environment (improved replication in mucin-treated hosts and retention in the respiratory tract) are mechanisms that can exploited as...
2
9
30
2025 starts with not less than 3 great medical microbiology papers on very diverse organisms SARS-CoV-2 (inflammatory peptide!) https://t.co/AnnN4qde9s Vibrio vulnificus (phylogeography) https://t.co/1r9lH4b4WY Pseudomonas aeruginosa (phage therapy)
nature.com
Communications Biology - Phage VAC3 adaptations to the mucosal environment (improved replication in mucin-treated hosts and retention in the respiratory tract) are mechanisms that can exploited as...
0
1
5
Olá pessoal! Sou servidora da Gerência Geral de Alimentos da Anvisa e doutoranda do Programa de Nutrição da UNB. Minha pesquisa é sobre o conhecimento do consumidor brasileiro sobre alegações de saúde em rótulos de alimentos e suplementos alimentares. Link no comentário
5
9
22
A 3-year postdoctoral position in antiphage immunity hosted by my lab (Lund), co-supervised @gem__atkinson (co-PI, structural bioinformatics, @lunduniversity) and Pontus Gourdon (co-PI, cryo-EM, Lund University and @uni_copenhagen). PleaseRT!
lu.varbi.com
Description of the workplace You will be based at the medical faculty in Lund. The group for molecular enzymology is located at the Biomedical Center (BMC) at Lund University and is led by senior lect
1
37
41
Looking for a postdoc in environmental virology? Fascinated by giant viruses and their glycobiology? We have a position available at the MPI for Marine Microbiology! @MarineMicrobio @HFSP @maxplanckpress
https://t.co/SEH7bSKz7J
1
30
42
📢 Historic day for Portugal and phage therapy! 🇵🇹 A framework was approved, allowing magistral preparation of personalized phage products. 🙌 Grateful to Jean-Paul Pirnay, my group @AzeredoLab Portuguese patients, and doctors who signed a petition inspired by the Belgium model.
25
60
266
We are scouting for a PhD student in antiphage immunity. Starting spring 2025 at @TartuUniversity, secondments at @lunduniversity. Please contact me with i) CV and ii) max 2-page cover letter (why you, why this topic and why our team) at vasili.hauryliuk@ut.ee. RT appreciated!
1
50
57